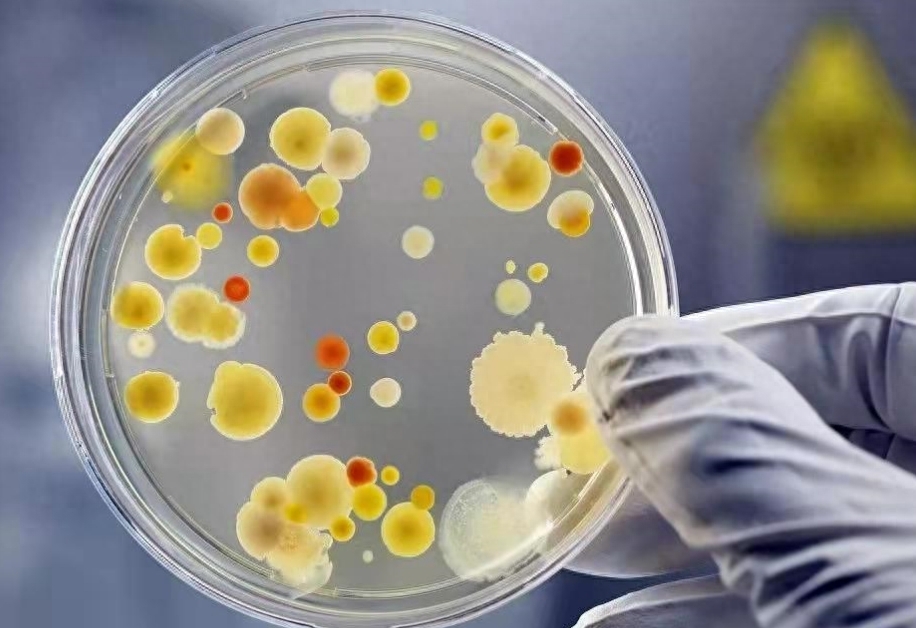
【名院名医】什么情况下要做痰培养?如何做呢?_治疗_细菌_类型

痰培养

痰细菌培养的临床应用
图片尺寸960x608
痰液培养
图片尺寸780x1040
诺卡痰培养
图片尺寸2000x4000
痰培养真的好恶心08我宁愿去画粑粑和尿#检验人日常
图片尺寸1080x1439
合川区中医院检验科第四十一次周学习:痰培养
图片尺寸2000x2666
合川区中医院检验科第四十一次周学习:痰培养
图片尺寸2000x2666
合川区中医院检验科第四十一次周学习:痰培养
图片尺寸2000x2666
痰培养:12h,长出大量曲霉菌
图片尺寸1280x960
痰培养~圣乔治努卡菌
图片尺寸2665x1999
患者痰培养标本(弱抗酸染色 ×1 000) a.
图片尺寸2756x974
痰培养中,上呼吸道的正常菌群长这样.
图片尺寸1200x1200
诺卡痰培养
图片尺寸2667x2000
诺卡痰培养
图片尺寸2667x2000
【名院名医】什么情况下要做痰培养?如何做呢?_治疗_细菌_类型
图片尺寸916x628
诺卡痰培养
图片尺寸2667x2000
咳咳做个痰培养一页手册协和八
图片尺寸657x320
痰培养中,下呼吸道分离出的致病菌.
图片尺寸1200x1200
青海省康乐医院检验科带您了解:带你了解痰培养
图片尺寸446x298
痰快速培养结核菌 药敏.
图片尺寸2000x2667
痰培养涂片的压片技巧
图片尺寸1920x1080